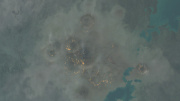

This special page shows all uploaded files.
| Date | Name | Thumbnail | Size | Description | Versions |
|---|---|---|---|---|---|
| 10:16, 12 August 2019 | Icon assault damage control.png (file) | 7 KB | Category:Items | 1 | |
| 17:33, 8 August 2019 | Guristas Shuttle.jpg (file) |  |
32 KB | Updated look | 2 |
| 17:32, 8 August 2019 | Goru's Shuttle.jpg (file) |  |
30 KB | Updated look | 2 |
| 14:02, 1 July 2019 | Fatimar Outpost.jpg (file) |  |
95 KB | Fatimar Outpost in MY-W1V Category:Lore | 1 |
| 13:36, 1 July 2019 | Minecore Facilities.jpg (file) |  |
215 KB | Minecore Facilities in K-X5AX Category:Lore | 1 |
| 13:25, 1 July 2019 | SteveMemorial.jpg (file) |  |
119 KB | new look | 2 |
| 13:11, 1 July 2019 | Blood Reach.jpg (file) |  |
158 KB | Blood Reach in CX8-6K Category:Lore | 1 |
| 11:24, 1 July 2019 | Abandoned research outpost.jpg (file) |  |
108 KB | abandoned research outpost beacon Category:Lore | 1 |
| 11:23, 1 July 2019 | PioneersSanctuary.jpg (file) |  |
92 KB | Category:lore | 1 |
| 10:53, 1 July 2019 | Abandoned Research Project.jpg (file) |  |
140 KB | Category:Lore | 1 |
| 10:40, 1 July 2019 | Rogue Cloning Facility.jpg (file) |  |
45 KB | Category:Lore | 1 |
| 10:34, 1 July 2019 | Abandoned Ship Wreck.jpg (file) |  |
67 KB | Category:Lore | 1 |
| 10:20, 1 July 2019 | Hollow Asteroid.jpg (file) |  |
70 KB | Hollow Asteroid in Djimame Category:Lore | 1 |
| 10:17, 1 July 2019 | Forgotten Amarr Outpost.jpg (file) |  |
130 KB | Category:Lore | 1 |
| 09:48, 1 July 2019 | Guristas Recruitment Center.jpg (file) |  |
84 KB | Guristas Recruitment Center in Taisy Category:Lore | 1 |
| 09:44, 1 July 2019 | Abandoned Guristas Transportation Facility.jpg (file) |  |
214 KB | Abandoned Guristas Transportation Facility in Nalvula Category:Lore | 1 |
| 09:39, 1 July 2019 | Abandoned Caldari Outpost.jpg (file) |  |
92 KB | Abandoned Caldari Outpost Category:Lore | 1 |
| 09:21, 1 July 2019 | Pandemic Legion Monument.jpg (file) |  |
187 KB | Pandemic Legion Monument in Amamake Category:Lore | 1 |
| 09:15, 1 July 2019 | Roden Center.jpg (file) |  |
146 KB | New look | 2 |
| 08:57, 1 July 2019 | Deserted Gallente Outpost.jpg (file) |  |
150 KB | Deserted Gallente Outpost location Category:Lore | 1 |
| 07:59, 1 July 2019 | Mysterious Shuttle.jpg (file) |  |
91 KB | New look | 2 |
| 07:49, 1 July 2019 | Wreck of TES Seraph.jpg (file) |  |
74 KB | Wreck of TES Seraph in Safizon Category:Lore | 1 |
| 07:43, 1 July 2019 | Choonka’s Ship-Wash.jpg (file) |  |
74 KB | New look | 2 |
| 07:28, 1 July 2019 | Journey of Katia Sae memorial.jpg (file) |  |
95 KB | Journey of Katia Sae memorial in Saisio Category:Lore | 1 |
| 20:22, 30 June 2019 | Municipal Junkyard.jpg (file) |  |
143 KB | modern look | 2 |
| 20:07, 30 June 2019 | Survey station.JPG (file) |  |
158 KB | Survey Station in Colelie Category:Lore | 1 |
| 19:51, 30 June 2019 | Arek'Jaalan Site One.jpg (file) |  |
72 KB | Arek'Jaalan Site One: Antiquus located in Eram Category:Lore | 1 |
| 19:34, 30 June 2019 | Jove observatory.jpg (file) |  |
197 KB | new image with better aspect ratio | 2 |
| 19:27, 30 June 2019 | Natural phenomenon.jpg (file) |  |
97 KB | changed aspect ratio | 2 |
| 19:22, 30 June 2019 | Yulai Graveyard and CONCORD Station.jpg (file) |  |
107 KB | changed aspect ratio | 3 |
| 19:20, 30 June 2019 | Operation highlander battleground.jpg (file) | |
51 KB | changed aspect ratio | 2 |
| 19:19, 30 June 2019 | Luminaire Graveyard.jpg (file) |  |
70 KB | Changed aspect ratio | 3 |
| 19:18, 30 June 2019 | Mysterious probe.jpg (file) |  |
67 KB | Mysterious Probe in Charmerout Category:Lore | 1 |
| 14:54, 28 May 2019 | Triglavian invasion WorldArkDetected.png (file) |  |
1 KB | Category:Icons | 1 |
| 14:54, 28 May 2019 | Triglavian invasion OutriftDetected.png (file) |  |
1 KB | Category:Icons | 1 |
| 14:54, 28 May 2019 | Triglavian invasion ScoutsReported.png (file) |  |
1 KB | Category:Icons | 1 |
| 14:53, 28 May 2019 | Triglavian invasion inretreat.png (file) |  |
1 KB | Category:Icons | 1 |
| 14:47, 28 May 2019 | Triglavian invasion sky.jpg (file) |  |
82 KB | 1 | |
| 13:31, 10 February 2019 | Icon standup ballistic control system.png (file) | 5 KB | Category:Items | 1 | |
| 08:56, 10 February 2019 | Icon standup reprocessing facility.png (file) | 6 KB | Category:Items | 1 | |
| 08:55, 10 February 2019 | Icon standup moon drill.png (file) | 7 KB | Category:Items | 1 | |
| 08:55, 10 February 2019 | Icon standup hybrid reactor.png (file) | 5 KB | Category:Items | 1 | |
| 08:55, 10 February 2019 | Icon standup composite reactor.png (file) | 7 KB | Category:Items | 1 | |
| 08:55, 10 February 2019 | Icon standup biochemical reactor.png (file) | 7 KB | Category:Items | 1 | |
| 08:54, 10 February 2019 | Icon standup manufacturing plant.png (file) | 6 KB | Category:Items | 1 | |
| 08:54, 10 February 2019 | Icon standup invention lab.png (file) | 6 KB | Category:Items | 1 | |
| 08:49, 10 February 2019 | Icon standup market hub.png (file) | 7 KB | Category:Items | 1 | |
| 08:48, 10 February 2019 | Icon standup cloning center.png (file) | 6 KB | Category:Items | 1 | |
| 08:48, 10 February 2019 | Icon standup ecm jammer burst projector.png (file) | 8 KB | Category:Items | 1 | |
| 08:47, 10 February 2019 | Icon standup weapon disruption burst projector.png (file) | 8 KB | Category:Items | 1 |
